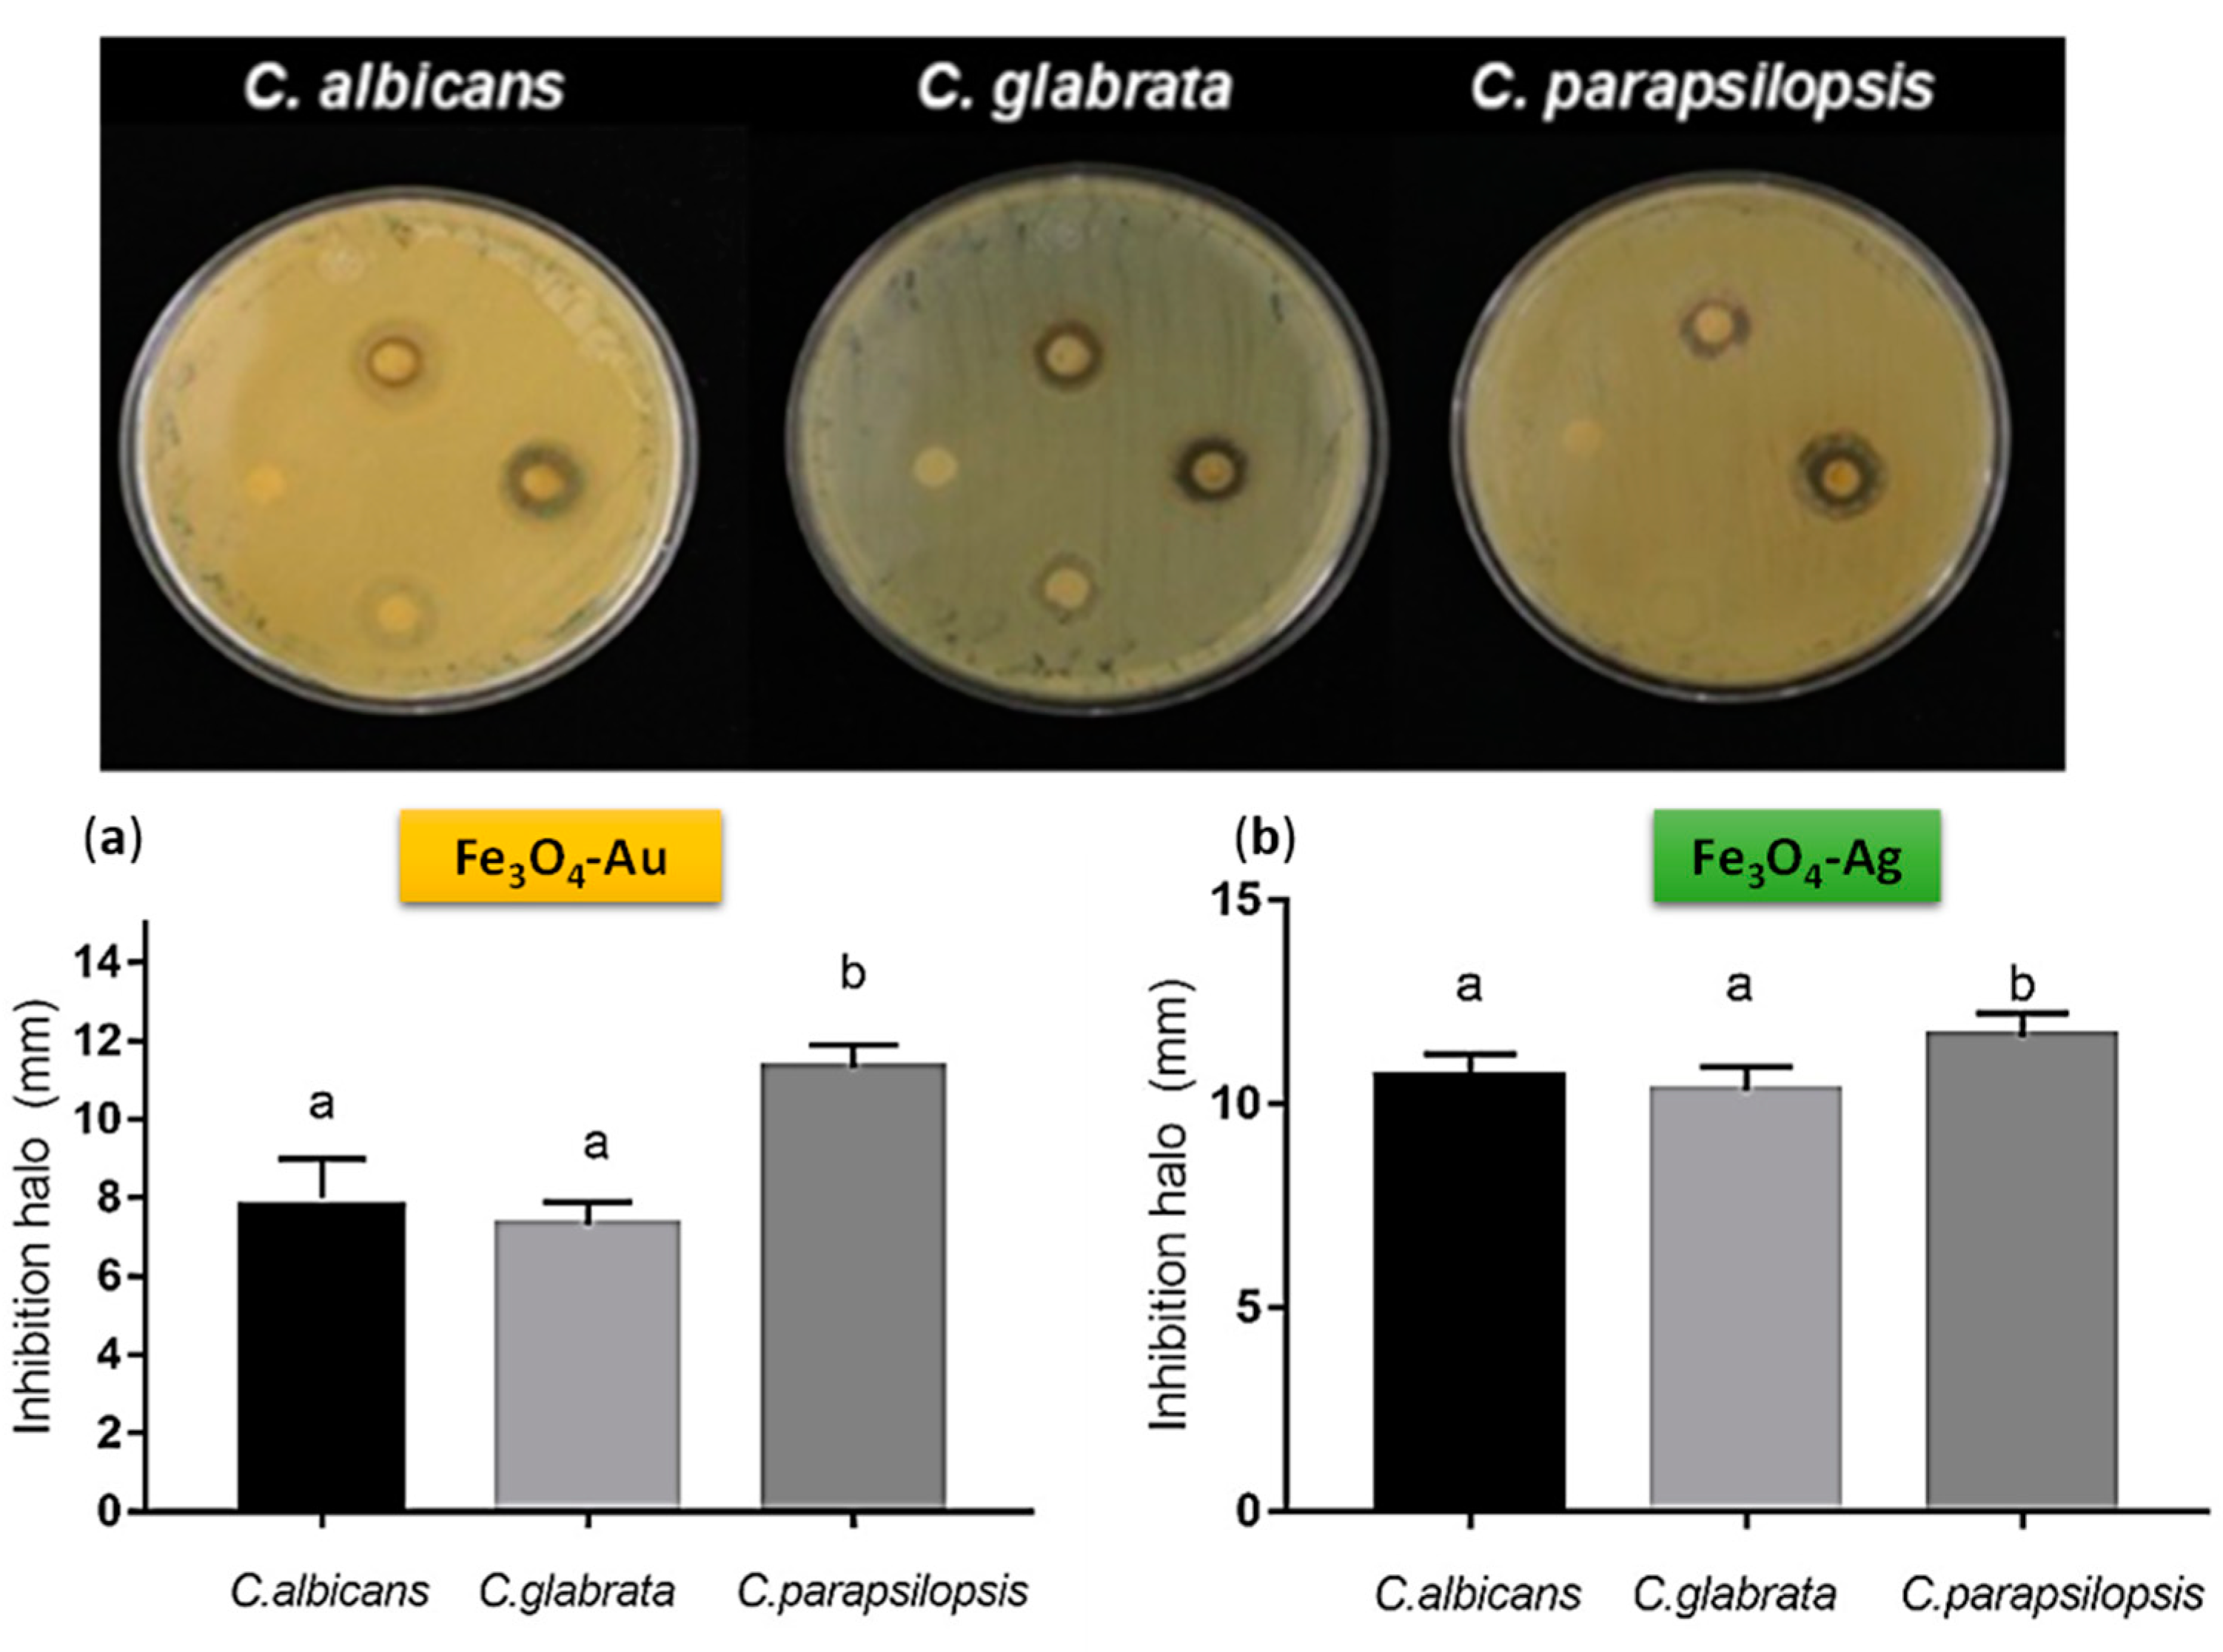

Green Ultrasound-Assisted Synthesis of Surface-Decorated Nanoparticles of Fe3O4 with Au and Ag: Study of the Antifungal and Antibacterial Activity
Abstract
1. Introduction
2. Materials and Methods
2.1. Green Synthesis of Magneto-Plasmonic Systems
2.2. X-ray Diffraction Analysis
2.3. Scanning Electron Microscopy (SEM)
2.4. Chemical Characterization
2.5. Antibiotic Assay
3. Results and Discussion
3.1. Materials Characterization
Scanning Electron Microscopy
3.2. X-Ray Diffraction Analysis and Williamson-Hall Methods (W-H)
Uniform Deformation Model (UDM)
3.3. Magnetic Properties
3.4. Antibacterial and Antifungal Activity Assay
4. Conclusions
Author Contributions
Funding
Institutional Review Board Statement
Informed Consent Statement
Data Availability Statement
Acknowledgments
Conflicts of Interest
References
- Kandasamy, G.; Maity, D. Multifunctional Theranostic Nanoparticles for Biomedical Cancer Treatments—A Comprehensive Review. Mater. Sci. Eng. C 2021, 127, 112199. [Google Scholar] [CrossRef]
- Lavorato, G.C.; Das, R.; Alonso Masa, J.; Phan, M.H.; Srikanth, H. Hybrid Magnetic Nanoparticles as Efficient Nanoheaters in Biomedical Applications. Nanoscale Adv. 2021, 3, 867–888. [Google Scholar] [CrossRef] [PubMed]
- Huang, J.; Lin, L.; Sun, D.; Chen, H.; Yang, D.; Li, Q. Bio-Inspired Synthesis of Metal Nanomaterials and Applications. Chem. Soc. Rev. 2015, 44, 6330–6374. [Google Scholar] [CrossRef]
- Husain, S.; Nandi, A.; Simnani, F.Z.; Saha, U.; Ghosh, A.; Sinha, A.; Sahay, A.; Samal, S.K.; Panda, P.K.; Verma, S.K. Emerging Trends in Advanced Translational Applications of Silver Nanoparticles: A Progressing Dawn of Nanotechnology. J. Funct. Biomater. 2023, 14, 47. [Google Scholar] [CrossRef]
- Menichetti, A.; Mavridi-printezi, A.; Mordini, D.; Montalti, M. Effect of Size, Shape and Surface Functionalization on the Antibacterial Activity of Silver Nanoparticles. J. Funct. Biomater. 2023, 14, 244. [Google Scholar] [CrossRef]
- Zhang, M.; Zhu, L.; Wang, J.; Ye, N.; Dai, S.; Yu, S.; Wu, Y. Surface Modification of Biomedical Metals by Double Glow Plasma Surface Alloying Technology: A Review of Recent Advances. J. Mater. Res. Technol. 2023, 24, 3423–3452. [Google Scholar] [CrossRef]
- Wirecka, R.; Maćkosz, K.; Żywczak, A.; Marzec, M.M.; Zapotoczny, S.; Bernasik, A. Magnetoresistive Properties of Nanocomposites Based on Ferrite Nanoparticles and Polythiophene. Nanomaterials 2023, 13, 879. [Google Scholar] [CrossRef] [PubMed]
- Lemine, O.M.; Algessair, S.; Madkhali, N.; Al-Najar, B.; El-Boubbou, K. Assessing the Heat Generation and Self-Heating Mechanism of Superparamagnetic Fe3O4 Nanoparticles for Magnetic Hyperthermia Application: The Effects of Concentration, Frequency, and Magnetic Field. Nanomaterials 2023, 13, 453. [Google Scholar] [CrossRef]
- Chernova, E.; Botvin, V.; Galstenkova, M.; Mukhortova, Y.; Wagner, D.; Gerasimov, E.; Surmeneva, M.; Kholkin, A.; Surmenev, R. A Comprehensive Study of Synthesis and Analysis of Anisotropic Iron Oxide and Oxyhydroxide Nanoparticles. Nanomaterials 2022, 12, 4321. [Google Scholar] [CrossRef]
- Jing, H.H.; Bardakci, F.; Akgöl, S.; Kusat, K.; Adnan, M.; Alam, M.J.; Gupta, R.; Sahreen, S.; Chen, Y.; Gopinath, S.C.B.; et al. Green Carbon Dots: Synthesis, Characterization, Properties and Biomedical Applications. J. Funct. Biomater. 2023, 14, 27. [Google Scholar] [CrossRef]
- Mocanu, A.C.; Miculescu, F.; Dascălu, C.A.; Voicu, Ș.I.; Pandele, M.A.; Ciocoiu, R.C.; Batalu, D.; Dondea, S.; Mitran, V.; Ciocan, L.T. Influence of Ceramic Particles Size and Ratio on Surface—Volume Features of the Naturally Derived HA-Reinforced Filaments for Biomedical Applications. J. Funct. Biomater. 2022, 13, 199. [Google Scholar] [CrossRef] [PubMed]
- Yu, L.; Zhu, S.; Qin, K.; Fan, X.; An, L. Macrophages Loaded with Fe Nanoparticles for Enhanced Photothermal Ablation of Tumors. J. Funct. Biomater. 2022, 13, 94. [Google Scholar] [CrossRef]
- Razumova, S.; Brago, A.; Barakat, H.; Howijieh, A.; Senyagin, A.; Serebrov, D.; Guryeva, Z.; Kozlova, Y.; Adzhieva, E. Evaluation of the Microbiological Effect of Colloidal Nanosilver Solution for Root Canal Treatment. J. Funct. Biomater. 2022, 13, 163. [Google Scholar] [CrossRef] [PubMed]
- Li, C.H.; Chan, M.H.; Chang, Y.C.; Hsiao, M. Gold Nanoparticles as a Biosensor for Cancer Biomarker Determination. Molecules 2023, 28, 364. [Google Scholar] [CrossRef]
- Tai, J.; Fan, S.; Ding, S.; Ren, L. Gold Nanoparticles Based Optical Biosensors for Cancer Biomarker Proteins: A Review of the Current Practices. Front. Bioeng. Biotechnol. 2022, 10, 877193. [Google Scholar] [CrossRef]
- Lee, S.; Lee, G.; Jeon, G.; Lee, H.; Park, S.; Sohn, Y.; Park, Y.; Ryu, S. Anti-Aging and Lightening Effects of Au-Decorated Zeolite-Based Biocompatible Nanocomposites in Epidermal Delivery Systems. J. Funct. Biomater. 2023, 14, 66. [Google Scholar] [CrossRef]
- Zamay, T.; Zamay, S.; Luzan, N.; Fedotovskaya, V.; Masyugin, A.; Zelenov, F.; Koshmanova, A.; Nikolaeva, E.; Kirichenko, D.; Veprintsev, D.; et al. Magnetic Nanoscalpel for the Effective Treatment of Ascites Tumors. J. Funct. Biomater. 2023, 14, 179. [Google Scholar] [CrossRef]
- Allafchian, A.; Hosseini, S.S. Antibacterial Magnetic Nanoparticles for Therapeutics: A Review. IET Nanobiotechnol. 2019, 13, 786–799. [Google Scholar] [CrossRef]
- Antonelli, A.; Magnani, M. SPIO Nanoparticles and Magnetic Erythrocytes as Contrast Agents for Biomedical and Diagnostic Applications. J. Magn. Magn. Mater. 2022, 541, 168520. [Google Scholar] [CrossRef]
- Wang, L.; Duan, Y.; Lu, S.; Sun, J. Magnetic Nanomaterials Mediate Electromagnetic Stimulations of Nerves for Applications in Stem Cell and Cancer Treatments. J. Funct. Biomater. 2023, 14, 58. [Google Scholar] [CrossRef] [PubMed]
- Arora, V.; Sood, A.; Kumari, S.; Kumaran, S.S.; Jain, T.K. Hydrophobically Modified Sodium Alginate Conjugated Plasmonic Magnetic Nanocomposites for Drug Delivery & Magnetic Resonance Imaging. Mater. Today Commun. 2020, 25, 101470. [Google Scholar] [CrossRef]
- Michałowska, A.; Żygieło, M.; Kudelski, A. Fe3O4-Protected Gold Nanoparticles: New Plasmonic-Magnetic Nanomaterial for Raman Analysis of Surfaces. Appl. Surf. Sci. 2021, 562, 150220. [Google Scholar] [CrossRef]
- Kobylinska, N.; Klymchuk, D.; Khaynakova, O.; Duplij, V.; Matvieieva, N. Morphology-Controlled Green Synthesis of Magnetic Nanoparticles Using Extracts of ‘Hairy’ Roots: Environmental Application and Toxicity Evaluation. Nanomaterials 2022, 12, 4231. [Google Scholar] [CrossRef]
- Khashan, S.; Dagher, S.; Tit, N.; Alazzam, A.; Obaidat, I. Novel Method for Synthesis of Fe3O4@TiO2 Core/Shell Nanoparticles. Surf. Coat. Technol. 2017, 322, 92–98. [Google Scholar] [CrossRef]
- Noqta, O.A.; Aziz, A.A.; Usman, I.A.; Bououdina, M. Recent Advances in Iron Oxide Nanoparticles (IONPs): Synthesis and Surface Modification for Biomedical Applications. J. Supercond. Nov. Magn. 2019, 32, 779–795. [Google Scholar] [CrossRef]
- Rudayni, H.A.; Shemy, M.H.; Aladwani, M.; Alneghery, L.M.; Abu-taweel, G.M.; Allam, A.A.; Abukhadra, M.R.; Bellucci, S. Synthesis and Biological Activity Evaluations of Green ZnO-Decorated Acid-Activated Bentonite-Mediated Curcumin Extract (ZnO@CU/BE) as Antioxidant and Antidiabetic Agents. J. Funct. Biomater. 2023, 14, 198. [Google Scholar] [CrossRef]
- Bonsignore, G.; Patrone, M.; Martinotti, S.; Ranzato, E. “Green” Biomaterials: The Promising Role of Honey. J. Funct. Biomater. 2021, 12, 72. [Google Scholar] [CrossRef] [PubMed]
- Fatimah, I.; Hidayat, H.; Purwiandono, G.; Khoirunisa, K.; Zahra, H.A.; Audita, R.; Sagadevan, S. Green Synthesis of Antibacterial Nanocomposite of Silver Nanoparticle-Doped Hydroxyapatite Utilizing Curcuma longa Leaf Extract and Land Snail (Achatina fulica) Shell Waste. J. Funct. Biomater. 2022, 13, 84. [Google Scholar] [CrossRef]
- Duel, P.; de las Nieves Piña, M.; Morey, J. One-Pot Environmentally Friendly Synthesis of Nanomaterials Based on Phytate-Coated Fe3O4 Nanoparticles for Efficient Removal of the Radioactive Metal Ions 90Sr, 90Y and (UO2)2+ from Water. Nanomaterials 2022, 12, 4383. [Google Scholar] [CrossRef] [PubMed]
- Mikhailova, E.O. Gold Nanoparticles: Biosynthesis and Potential of Biomedical Application. J. Funct. Biomater. 2021, 12, 70. [Google Scholar] [CrossRef]
- Longo, R.; Vertuccio, L.; Speranza, V.; Pantani, R.; Raimondo, M.; Calabrese, E.; Guadagno, L. Nanometric Mechanical Behavior of Electrospun Membranes Loaded with Magnetic Nanoparticles. Nanomaterials 2023, 13, 1252. [Google Scholar] [CrossRef] [PubMed]
- Mamani, J.B.; Gamarra, L.F.; De Souza Brito, G.E. Synthesis and Characterization of Fe3O4 Nanoparticles with Perspectives in Biomedical Applications. Mater. Res. 2014, 17, 542–549. [Google Scholar] [CrossRef]
- de Jesús Ruíz-Baltazar, Á. Sonochemical Activation-Assisted Biosynthesis of Au/Fe3O4 Nanoparticles and Sonocatalytic Degradation of Methyl Orange. Ultrason. Sonochem. 2021, 73, 105521. [Google Scholar] [CrossRef] [PubMed]
- Dheyab, M.A.; Aziz, A.A.; Jameel, M.S.; Khaniabadi, P.M.; Mehrdel, B. Mechanisms of Effective Gold Shell on Fe3O4 Core Nanoparticles Formation Using Sonochemistry Method. Ultrason. Sonochem. 2020, 64, 104865. [Google Scholar] [CrossRef]
- Khameneh, B.; Iranshahy, M.; Soheili, V.; Sedigheh, B.; Bazzaz, F. Review on Plant Antimicrobials: A Mechanistic Viewpoint. Antimicrob. Resist. Infect. Control 2019, 6, 118. [Google Scholar] [CrossRef] [PubMed]
- Galai, M.; Rbaa, M.; Ouakki, M.; Dahmani, K.; Kaya, S.; Arrousse, N.; Dkhireche, N.; Briche, S.; Lakhrissi, B.; Ebn Touhami, M. Functionalization Effect on the Corrosion Inhibition of Novel Eco-Friendly Compounds Based on 8-Hydroxyquinoline Derivatives: Experimental, Theoretical and Surface Treatment. Chem. Phys. Lett. 2021, 776, 138700. [Google Scholar] [CrossRef]
- Ren, Z.; Chhetri, A.; Guan, Z.; Suo, Y.; Yokoyama, K.; Lee, S. Structural Basis for Inhibition and Regulation of a Chitin Synthase from Candida albicans. Nat. Struct. Mol. Biol. 2022, 29, 653–664. [Google Scholar] [CrossRef]
- Muşat, V.; Crintea, L.; Anghel, E.M.; Stănică, N.; Atkinson, I.; Culiţă, D.C.; Baroiu, L.; Țigău, N.; Cantaragiu Ceoromila, A.; Botezatu, A.V.; et al. Ag-Decorated Iron Oxides-Silica Magnetic Nanocomposites with Antimicrobial and Photocatalytic Activity. Nanomaterials 2022, 12, 4452. [Google Scholar] [CrossRef]
- Itrat, S.; Naqvi, Z.; Kausar, H.; Afzal, A.; Hashim, M.; Mujahid, H.; Javed, M.; Hano, C.; Anjum, S. Antifungal Activity of Juglans-Regia-Mediated Silver Nanoparticles (AgNPs) against Aspergillus-Ochraceus-Induced Toxicity in In Vitro and In Vivo Settings. J. Funct. Biomater. 2023, 14, 221. [Google Scholar]
- Hashem, A.H.; Saied, E.; Amin, B.H.; Alotibi, F.O.; Al-Askar, A.A.; Arishi, A.A.; Elkady, F.M.; Elbahnasawy, M.A. Antifungal Activity of Biosynthesized Silver Nanoparticles (AgNPs) against Aspergilli Causing Aspergillosis: Ultrastructure Study. J. Funct. Biomater. 2022, 13, 242. [Google Scholar] [CrossRef]
- Dilshad, E.; Bibi, M.; Sheikh, N.A.; Tamrin, K.F.; Mansoor, Q.; Maqbool, Q.; Nawaz, M. Synthesis of Functional Silver Nanoparticles and Microparticles with Modifiers and Evaluation of Their Antimicrobial, Anticancer, and Antioxidant Activity. J. Funct. Biomater. 2020, 11, 76. [Google Scholar] [CrossRef] [PubMed]
- Sobral, R.; Tomasz, A. The Staphylococcal Cell Wall. In Gram-Positive Pathogens, 3rd ed.; ASM Press: Washington, DC, USA, 2019; pp. 574–591. [Google Scholar] [CrossRef]
- Fosca, M.; Streza, A.; Antoniac, I.V.; Vadalà, G.; Rau, V. Ion-Doped Calcium Phosphate-Based Coatings with Antibacterial Properties. J. Funct. Biomater. 2023, 14, 250. [Google Scholar] [CrossRef] [PubMed]
- Gupta, N.; Gupta, C.; Bohidar, H.B. Visible Laser Light Mediated Cancer Therapy via Photothermal Effect of Tannin-Stabilized Magnetic Iron Oxide Nanoparticles. Nanomaterials 2023, 13, 1456. [Google Scholar] [CrossRef]
- de Jesús Ruíz-Baltazar, Á. Green Synthesis Assisted by Sonochemical Activation of Fe3O4-Ag Nano-Alloys: Structural Characterization and Studies of Sorption of Cationic Dyes. Inorg. Chem. Commun. 2020, 120, 108148. [Google Scholar] [CrossRef]
- de Jesus Ruíz-Baltazar, Á. Kinetic Adsorption Models of Silver Nanoparticles Biosynthesized by Cnicus Benedictus: Study of the Photocatalytic Degradation of Methylene Blue and Antibacterial Activity. Inorg. Chem. Commun. 2020, 120, 108158. [Google Scholar] [CrossRef]
- Irfan, H.; Mohamed Racik, K.; Anand, S. Microstructural Evaluation of CoAl2O4 Nanoparticles by Williamson–Hall and Size–Strain Plot Methods. J. Asian Ceram. Soc. 2018, 6, 54–62. [Google Scholar] [CrossRef]
- Zak, A.K.; Majid, W.A.; Abrishami, M.E.; Yousefi, R. X-ray Analysis of ZnO Nanoparticles by Williamson-Hall and Size-Strain Plot Methods. Solid State Sci. 2011, 13, 251–256. [Google Scholar] [CrossRef]
- Li, D.; Hu, Y.; Wei, H.; Chen, W.; Liu, Y.; Yan, X.; Guo, L.; Liao, M.; Chen, B.; Chai, R.; et al. Superparamagnetic Iron Oxide Nanoparticles and Static Magnetic Field Regulate Neural Stem Cell Proliferation. Front. Cell. Neurosci. 2022, 15, 583. [Google Scholar] [CrossRef]
- Sirgedaite, G.; Talaikis, M.; Niaura, G.; Mikoliunaite, L. Magneto-Plasmonic Nanostructures for SERS: Magnetite Decorated by Silver and Gold Nanoparticles. New J. Chem. 2022, 47, 402–411. [Google Scholar] [CrossRef]
- Romaniuk, J.A.H.; Cegelski, L. Bacterial Cell Wall Composition and the Influence of Antibiotics by Cell-Wall and Whole-Cell NMR. Philos. Trans. R. Soc. B Biol. Sci. 2015, 370, 20150024. [Google Scholar] [CrossRef]
- Trofa, D.; Gácser, A.; Nosanchuk, J.D. Candida Parapsilosis, an Emerging Fungal Pathogen. Clin. Microbiol. Rev. 2008, 21, 606–625. [Google Scholar] [CrossRef] [PubMed]
- Nair Silva-Holguín, P.; de Jesús Ruíz-Baltazar, Á.; Yobanny Reyes-López, S. Antimicrobial Study of the Al2O3-Cu and Al2O3-Hydroxiapatite-Cu Spheres. Inorg. Chem. Commun. 2022, 138, 109253. [Google Scholar] [CrossRef]
- Estrada-Mata, E.; Navarro-Arias, M.J.; Pérez-García, L.A.; Mellado-Mojica, E.; López, M.G.; Csonka, K.; Gacser, A.; Mora-Montes, H.M. Members of the Candida parapsilosis Complex and Candida albicans Are Differentially Recognized by Human Peripheral Blood Mononuclear Cells. Front. Microbiol. 2016, 6, 1527. [Google Scholar] [CrossRef]
- Salama, A.; Saleh, A.K.; Cruz-Maya, I.; Guarino, V. Bacterial Cellulose/Cellulose Imidazolium Bio-Hybrid Membranes for In Vitro and Antimicrobial Applications. J. Funct. Biomater. 2023, 14, 60. [Google Scholar] [CrossRef]
- D’Orto, B.; Chiavenna, C.; Leone, R.; Longoni, M.; Nagni, M.; Capparè, P. Marginal Bone Loss Compared in Internal and External Implant Connections: Retrospective Clinical Study at 6-Years Follow-Up. Biomedicines 2023, 11, 1128. [Google Scholar] [CrossRef] [PubMed]
- Qi, M.; Chi, M.; Sun, X.; Xie, X.; Weir, M.D.; Oates, T.W.; Zhou, Y.; Wang, L.; Bai, Y.; Xu, H.H.K. Novel Nanomaterial-Based Antibacterial Photodynamic Therapies to Combat Oral Bacterial Biofilms and Infectious Diseases. Int. J. Nanomed. 2019, 14, 6937–6956. [Google Scholar] [CrossRef] [PubMed]
- Chi, M.; Li, N.; Cui, J.; Karlin, S.; Rohr, N.; Sharma, N.; Thieringer, F.M. Biomimetic, Mussel-Inspired Surface Modification of 3D-Printed Biodegradable Polylactic Acid Scaffolds with Nano-Hydroxyapatite for Bone Tissue Engineering. Front. Bioeng. Biotechnol. 2022, 10, 1646. [Google Scholar] [CrossRef] [PubMed]
- Li, W.; Qi, M.; Sun, X.; Chi, M.; Wan, Y.; Zheng, X.; Li, C.; Wang, L.; Dong, B. Novel Dental Adhesive Containing Silver Exchanged EMT Zeolites against Cariogenic Biofilms to Combat Dental Caries. Microporous Mesoporous Mater. 2020, 299, 110113. [Google Scholar] [CrossRef]

| Sample | Ms (Am2/kg) | Mrs (Am2/kg) | Bc (mT) |
| Fe3O4 | 4340 | 147 | 1.4 |
| Fe3O4-Ag | 217 | 4.25 | 1.0 |
| Fe3O4-Au | 120,000 | 304 | 0.2 |
Disclaimer/Publisher’s Note: The statements, opinions and data contained in all publications are solely those of the individual author(s) and contributor(s) and not of MDPI and/or the editor(s). MDPI and/or the editor(s) disclaim responsibility for any injury to people or property resulting from any ideas, methods, instructions or products referred to in the content. |
© 2023 by the authors. Licensee MDPI, Basel, Switzerland. This article is an open access article distributed under the terms and conditions of the Creative Commons Attribution (CC BY) license (https://creativecommons.org/licenses/by/4.0/).
Share and Cite
Ruíz-Baltazar, Á.d.J.; Böhnel, H.N.; Larrañaga Ordaz, D.; Cervantes-Chávez, J.A.; Méndez-Lozano, N.; Reyes-López, S.Y. Green Ultrasound-Assisted Synthesis of Surface-Decorated Nanoparticles of Fe3O4 with Au and Ag: Study of the Antifungal and Antibacterial Activity. J. Funct. Biomater. 2023, 14, 304. https://doi.org/10.3390/jfb14060304
Ruíz-Baltazar ÁdJ, Böhnel HN, Larrañaga Ordaz D, Cervantes-Chávez JA, Méndez-Lozano N, Reyes-López SY. Green Ultrasound-Assisted Synthesis of Surface-Decorated Nanoparticles of Fe3O4 with Au and Ag: Study of the Antifungal and Antibacterial Activity. Journal of Functional Biomaterials. 2023; 14(6):304. https://doi.org/10.3390/jfb14060304
Chicago/Turabian StyleRuíz-Baltazar, Álvaro de Jesús, Harald Norbert Böhnel, Daniel Larrañaga Ordaz, José Antonio Cervantes-Chávez, Néstor Méndez-Lozano, and Simón Yobanny Reyes-López. 2023. "Green Ultrasound-Assisted Synthesis of Surface-Decorated Nanoparticles of Fe3O4 with Au and Ag: Study of the Antifungal and Antibacterial Activity" Journal of Functional Biomaterials 14, no. 6: 304. https://doi.org/10.3390/jfb14060304
APA StyleRuíz-Baltazar, Á. d. J., Böhnel, H. N., Larrañaga Ordaz, D., Cervantes-Chávez, J. A., Méndez-Lozano, N., & Reyes-López, S. Y. (2023). Green Ultrasound-Assisted Synthesis of Surface-Decorated Nanoparticles of Fe3O4 with Au and Ag: Study of the Antifungal and Antibacterial Activity. Journal of Functional Biomaterials, 14(6), 304. https://doi.org/10.3390/jfb14060304

